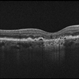
Geographic Atrophy in Dry AMD Geographic Atrophy in Dry AMD

-
By Darin R. Goldman, MD
Retina Group of Florida - Uploaded on Oct 14, 2015.
- Last modified by Caroline Bozell on Oct 15, 2015.
- Rating
- Appears in
- Miscellaneous
- Description
- 55-year-old female with multiple prior primary systemic cancers. She presented with a choroidal tumor, felt to be a primary choroidal melanoma, that had ruptured Bruch's membrane, causing subretinal hemorrhage.


 Initializing download.
Initializing download.